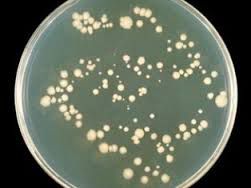
image

Главная причина заболевания – рост грибка Candida albicans, являющегося условно-патогенным, что означает их постоянное присутствие на слизистых полостях организма. В основном передается при половом акте.
Генитальный кандидоз имеет другое название – молочница половых органов, если другие виды молочницы встречаются часто, то генитальный кандидоз не особо распространен. Но это не означает, что вы не должны о нем знать, он способен поразить каждого. Не беспокойтесь, это не венерическое заболевание, хотя и имеет схожие симптомы.
Причины
Большинство людей имеет грибок рода candida чуть ли не с самого детства, и его наличие в организме не причиняет вреда и никак не проявляется, поскольку количество грибка постоянно регулируется. Но некоторые обстоятельства дают грибку преимущество, из-за чего происходит их патогенное размножение.
Кандидоз гениталий развивается под влиянием различных факторов, воздействующих на сопротивляемость организма. Эти факторы могут быть внутренние и внешние.
Внешние факторы, приводящие к размножению грибка, в себя включают:
- Высокую влажность. Если человек часто потеет (гипергидроз), то у него высоки шансы развития кандидоза. А еще у работников водных сфер деятельности, поскольку тепло и влага – условия для размножения грибка.
- Влияние химических средств на кожу.
- Долго нахождение в помещениях, с высокой концентрацией грибка в атмосфере. Например, на консервных фабриках, овощехранилищах и т.д.
- Длительный прием антибиотиков, которые воздействуют на микрофлору организма, предоставляя грибку условия для развития.
- Некачественная гигиена. Паховый кандидоз развивается у детей при не частой смене подгузников или у пациентов, неспособных двигаться.
Внутренние же факторы таковы:
- Изменение микрофлоры.
- Нарушения метаболизма.
- Авитаминоз.
- Ослабление защитных свойств кожи при воспалениях (инфекциях).
Основной фактор развития кандидоза – ослабление иммунитета, что происходит в таких случаях:
- принятия оральных контрацептивов;
- ВИЧ-инфицирование;
- стресс и эмоциональное напряжение;
- сезонные гиповитаминозов;
- нарушение процессов обмена веществ;
- смена климата;
- наличие воспалительных процессов в организме;
- химиотерапия, проводимая для лечения злокачественных образований.
Следите за состоянием здоровья, пользуйтесь методами профилактики и периодически посещайте врача. Во избежание повторного заболевания, кроме симптомов, устраняйте причину возникновения, возможно, что появление кандидоза связано с одной из перечисленных причин.
Симптомы
Для женщины генитальный кандидоз характерен жжением и зудом снаружи половых органов, особенно усиливающимся ночью. Половой акт и мочеиспускание сопровождаются болью, а в паховой области наблюдаются специфические творожистые выделения белого или желтоватого цвета, иногда густые, но бывают и жидкие.
На складках влагалища заметен серый налет из клеток псевдомицелия. При острой форме встречаются отдельные группы налета, а при хронической они сливаются вместе. Влагалище отекает, развивается гиперемия. А после снятия налета слизистая кровоточит.
У мужчин специфической особенностью будет жжение и зуд в районе крайней плоти, а на головке полового члена появляется налет. На крайней плоти происходит покраснение, иногда возникающее и на головке члена. При половом акте и мочеиспускании в паху присутствует усиливающаяся боль.
20 % малышей, не проживших еще и года, сталкиваются с молочницей. Преимущественное количество случаев возникновения молочницы у детей связано с проявлениями в ротовой полости, а в паху заболевание возникает при сильно ослабленном иммунитете организма ребенка, и является составляющей при пеленочном дерматите.
Характерными являются гиперемия и сильные раздражения, которые быстро распространяются по коже в области паха и меж ягодиц. Если у младенца присутствуют подобные симптомы, стоит обратится к педиатру. Не рискуйте здоровьем ребенка, пытаясь вылечить заболевание самостоятельно.
Урогенитальный кандидоз паховых складок имеет три формы: носитель грибка, острый кандидоз и хронический кандидоз.
На ранних стадиях заболевание способно иметь стертые формы проявления, причиняя минимум дискомфорта человеку, а симптоматика не проявляется, или незначительна. При этом наблюдается слабый зуд, а на выделения практически никто не обращает внимания. Обращения к врачу на этой стадии крайне редки, а молочница определяется случайно.
Чаще всего встречается острая форма заболевания, для которой характерны отеки, воспаления и высыпания на слизистых поверхностях и на коже, гиперемия. Острая форма протекает не более двух месяцев.
Хроническая форма имеет длительное течение, и на слизистых поверхностях присутствует атрофия тканей и инфильтрация.
С молочницей знакома чуть ли не каждая женщина, однако при подобных симптомах не стоит подозревать только развитие кандидоза. Не списывайте симптомы на обострение молочницы, ведь по ошибке можно не заметить другие болезни, более серьезные, чем молочница. Точную причину проявлений вам назовет врач после диагностики.
Диагностика

Генитальный кандидоз диагностируется методом сбора мазка из влагалища или полового члена. Далее полученный материал проверяют под микроскопом, где обнаруживают мицелий грибка. Затем производится посев мазка, чтобы определить чувствительность грибка к антибиотику.
Выявляют наличие возможных сопутствующих заболеваний, что производится при помощи серологических исследований. Чаще всего молочница развивается с другими заболеваниями половых путей. Чтобы определить это сдается анализ на сахар для исключения сахарного диабета. Проходит обследование на ВИЧ. Для взрослых кандидоз паховых складок определяется обследованием на ЗППП. Также к диагностике привлекаются уролог или гинеколог, если молочница протекает у женщин вместе с вагинальным кандидозом, а у мужчин с баланопоститом.
Чтобы отличить молочницу от псориаза паховых складок, эритематозной волчанки, себорейного дерматита или герпеса иногда проводят дифференциальную диагностику.
Перед диагностикой желательно воздержаться от половых контактов, не применять гели, таблетки и кремы, которые врач не назначал.
Сутра не подмывайтесь, и за пару часов до посещения врача не ходите в туалет. Перед походом в больницу противопоказаны спринцевания.
Лечение
Генитальный кандидоз имеет комплексное лечение. Сперва необходимо уничтожить возбудитель и убрать дополнительные заболевания. Лечение лучше проходить обоим партнерам, даже если болен только один. Самостоятельно устранить грибок в паху не получится. Самолечение, препараты из рекламы и советы друзей лишь ведут к осложнению заболевания. Течение болезни у каждого индивидуально, и поэтому врач не просто так выписывает определенные препараты.
Во время беременности выбор препаратов для женщин ограничен. Учтите это, не занимайтесь самолечением, а лучше идите к специалисту.
При локализованном (местном) лечении в качестве средства борьбы с грибком используются вагинальные свечи, мази и таблетки. Основными преимуществами этого вида лечение являются:
- Отсутствие большого количества противопоказаний;
- Поскольку препараты влияют на грибок непосредственно в месте его нахождения, то общее влияние веществ на организм минимально, что ограждает пациента от вреда;
- Лечение удобно как мужчинам, так и женщинам;
- Препараты не всасываются, и остаются непосредственно на пораженном участке кожи, оказывая эффект максимально долго;
- Среди побочных эффектов чаще всего встречается только аллергия.
А вот среди недостатков можно выделить следующие:
- Если заболевания находится в хронической форме, то действия таких препаратов будет просто недостаточно.
- Лечение такими медикаментами происходит методично, от одной до двух недель.
Действующие вещества препаратов местного лечения имеют сильный лечебный эффект. В основном это:
Чтобы усилить действие местных препаратов выписывают системные средства борьбы с кандидозом. Это таблетки для приема внутрь и капсулы. Действующие вещества в этих препаратах в основном такие:
На самом же деле действующих препаратов больше, однако эти — наиболее действенные.
Несмотря на иллюзионное удобство приема таблеток, это не самый оптимальный вариант. Иногда достаточно одного применения, но действующие вещества быстро разносятся кровью по организму. Из-за этого велик риск возникновения побочных эффектов и количества противопоказаний.
Молочница известна давно, и в народной медицине есть много рецептов, помогающих ее вылечить. Однако лечение такими методами не должно быть основным, а лишь выступать в качестве дополнения. Народные рецепты :
Сделать из соды и воды густую массу, напоминающую пасту, и обработать ей складки на половых органах. Подождать пока засохнет, снять, соблюдая аккуратность и нанести на пораженный участок детскую присыпку или крахмал.
Примочки из сбора трав (кора дуба, череда, тысячелистник, семена льна). Следует залить травы кипятком, сделать отвар, дать ему настоятся и процедить. Примочки делать только с теплым настоем в течение 15-ти минут.
При молочнице помогает стакан морковного сока перед приемом пищи. Но в день – не более двух стаканов.
Сильное действие оказывает чеснок. Раздавите три дольки, и залейте литром теплой воды. Полученный раствор применять для спринцеваний.
Из них можно делать растворы для спринцеваний, проводить обмывание гениталий, применять для компрессов. Правильно сочетать лечение народными методами с основным курсом терапии поможет доктор.
Профилактика

- Соблюдайте чистоту промежности и не нарушайте личную гигиену;
- Следите за употреблением сахара – его не стоит есть много;
- Обогатите рацион кисломолочными натуральными продуктами;
- Для гигиены не используйте чересчур густые и концентрированные гели. Спреи и гели в форме дезодорантов лучше не применять;
- От синтетического обтягивающего белья лучше отказаться, а предпочтительно – свободное белье из натуральных материалов;
- При частых посещениях бассейна не носите долго влажный купальный костюм.
Несмотря на то, что молочница считается не столь опасным заболеванием, иногда ее несвоевременное выявление и лечение приводит к осложнениям. Поэтому не забывайте посещать врача для общего осмотра, чтобы вовремя предостеречь себя от болезни.
При генитальном кандидозе условно-патогенные микроорганизмы поражают слизистую оболочку внутренних и наружных половых органов. Развитие грибка происходит при создании оптимальных для этого условий. Генитальный кандидоз не относится к венерическим заболеваниям, но имеет схожую с ними симптоматику.
Генитальный кандидоз: что это
Молочница относится к самым распространенным заболеваниям, он встречается независимо от возраста и пола, но чаще всего диагностируется у людей, которые ведут активную половую жизнь. Полностью устранить генитальный кандидоз практически невозможно.
Пациент однажды переболевший ей будет вынужден регулярно проходить профилактический курс лечения.
Грибки, вызывающие нарушение в организме являются частью микрофлоры половой системы. В организме здорового человека кандиды вынуждены вести пассивный образ жизни, поскольку их деятельность регулирует иммунная система. Рост численности грибов происходит под воздействием внешних и внутренних факторов, этому способствует:
- длительный прием антибиотиков;
- изменение гормонального фона во время беременности, менопаузы или нарушения в организме;
- употребление оральных контрацептивов;
- заболевания влияющие на иммунитет, это может быть туберкулез, СПИД или диабет;
- неправильное питание;
- недостаток витаминов в организме;
- расстройство нервной системы;
- нарушение работы желудочно-кишечного тракта;
- смена климата;
- использование некачественного нижнего белья.
По принципу распространенности выделяют следующие виды генитального кандидоза:
- Системный. Страдают внешние и внутренние половые органы. Он появляется при иммунной недостаточности, диабете и туберкулезе.
- Поверхностный. Воздействию грибков подвергаются наружные гениталии. Заболевание имеет легкое течение и часто наблюдается у пожилых людей.
- Кандидозный сепсис. Наиболее опасная форма патологии. Дрожжеподобные грибки попадают в кровь и начинают распространяться по всему организму.
Как передается кандидоз половых органов
Генитальный кандидоз появляется у мужчин и женщин. Преимущественно он передается половым путем. Оральные контрацептивы не способны защитить человека от вероятного инфицирование, поэтому врачи советуют использовать только презервативы. Заражение половым путем при его применении возможно только при повреждении контрацептива.
Инфицирование происходит во время орально-генитальных ласк. Генитальный кандидоз локализуется в паху, но грибки могут распространяться по всему организму. Слизистая ротовой полости подходит для развития кандид, располагаясь там они длительное время не проявляют себя. Достаточно чувственного поцелуя для того, чтобы передать инфекцию другому человеку.
Также существует непрямой способ заражения, он происходит через средства личной гигиены и домашнего обихода. Грибки способны на протяжении нескольких часов находиться на поверхности нижнего, постельного белья, мясе, овощах, столовых приборах и личных вещах. Поэтому необходимо соблюдать личную гигиену и при наличии любых подозрений обращаться к врачу, чтобы не выступать в роли носителя кандидоза.
Симптомы и признаки
Поражение кожных покровов является очевидным и характерным признаком нарушения.
На пораженных участках образуются эрозии и белый налет. Генитальный кандидоз в зависимости от симптоматики может быть везикулезный и эритематозный. В первом случае наблюдается сильный отек, покраснение тканей и образование пузырьков. Эритематозный кандидоз сопровождается покраснением и эрозиями на месте развития грибков.
У женщин генитальная форма молочницы не имеет ярких проявлений на начальном этапе. Может наблюдаться легкий зуд и бели, но эти симптомы не доставляют неудобства. По мере развития кандидоза патология распространяется на влагалище и область половых губ. На фоне незаметного течения периодически появляются обострения, они наблюдаются перед месячными или во время них.
Затем воспаляется кожный покров в области паха, появляется отек и сильный зуд. Дискомфорт усиливается к вечеру, ощущения становятся невыносимыми. По мере развития генитального кандидоза пациентка будет наблюдать у себя образование пустул и папул. После того как пузырьки с жидкостью лопнут, на их месте появится эрозийная корочка. Появятся водянистые или густые выделения из половых органов. При поражении мочеполовой системы возникнет боль во время справления нужды.
У мужчин при генитальном кандидозе появляется зуд и жжение в области пениса. Крайняя плоть и головка полового члена краснеет, могут наблюдаться творожистые выделения. Проявления молочницы у мужчин ярко выражены во время занятий сексом. Наблюдается жжение и боль, при отсутствии лечения возникают проблемы с эрекцией.
Комплексный подход к лечению
При обращении к специалисту врач подберет лекарства направленные на подавление дрожжеподобной флоры. При обнаружении заболевания на раннем этапе удастся избежать назначения сильнодействующих препаратов. Если удалось избежать осложнений и заболевание не успело прогрессировать, то прием медикаментов займет не более 7 дней. Запущенные формы генитального кандидоза лечатся на протяжении нескольких месяцев.
Составление терапии при лечении кандидоза осуществляется на основе индивидуальных особенностей организма. Не стоит пытаться самостоятельно подбирать лекарства или опираться на рекомендации друзей.
Составить план лечения способен только врач после диагностического обследования.
Народные средства используются на начальном этапе развития молочницы. В большинстве случаев их применяют в качестве вспомогательного элемента, для ослабления симптомов и поддержки иммунитета. Употребляют травяные настои и отвары для спринцевания. Допустимо использование:
В зависимости от симптомов, общего самочувствия и наличия сопутствующих заболеваний подбирается лекарство. Их выбирают в зависимости от действующего вещества:
- Триазолы. Антибактериальные препараты оказывают быстрый эффект. Наиболее популярен дифлюкан, микосист, флюкостат. Разовая дозировка этих лекарств не должна превышать 150 мг. На ранних этапах генитального кандидоза достаточно разового употребления таблетки, в обратном случае лекарство употребляют на протяжении 5 дней.
- Макролиды. Их могут назначить для употребления внутрь или местно. В эту группу входит натамацин и пимафуцин. Продолжительность приема данных лекарств не превышает 10 дней.
- Полиены. Врачи назначают медикаменты на протяжении 10 дней. Наиболее эффективен нистатин и бифоназол.
- Глококортикостероиды. Комбинированные препараты устраняют воспаление и влияют на возбудителя генитального кандидоза. Лекарства выпускают в форме мазей или вагинальных свечей. Их употребляют на протяжении нескольких недель. Наиболее эффективен октицил, тержинан, полижинакс.
- На основе клотримазола. Препараты с этим действующим веществом имеют самую доступную цену. В эту группу входит канизон, тридерм, канестен.
При легкой форме кандидоза достаточно местных препаратов для устранения дискомфорта, это могут быть вагинальные свечи или таблетки. Во время лечения женщины должны подмываться теплой водой 2 раза в день, для удобства можно использовать губку. Рекомендуется выбирать специальный интимный гель для гигиены без антибактериального эффекта, он позволят избежать пересушивания слизистой оболочки.
Местные препараты подбираются на основе миконазола, клотримазола и бутоконазола. Для внутреннего употребления назначается кетоконазол, итраконазол или флуконазол.
Женщинам в положении при лечении генитального кандидоза преимущественно назначают местные препараты, поскольку они не всасываются в кровь, а значит не оказывают воздействия на развитие эмбриона.
Из системных препаратов врач может назначить пимафуцин или нистатин. Также выписывают местные противовоспалительные средства. Это может быть раствор зеленки или буры в глицерине. Ими обрабатывают стенки влагалища перед сном.
Во время беременности врач назначает лекарство на основе срока, состояния женщины и младенца, самолечение недопустимо.
Представители сильного пола быстрее избавляются от генитального кандидоза в связи с физиологическими особенностями. Им также необходимо регулярно принимать душ, особенно при наличии выделений из головки полового члена.
Назначаются местные крема с противогрибковым эффектом (наиболее распространен нистатин) и системные препараты.
Меры профилактики
Полностью избавиться от генитального кандидоза достаточно сложно, поэтому проще предупредить патологию, чем длительное время заниматься ее лечением. Меры профилактики подразумевают:
- отсутствие незащищенных половых связей;
- ведение здорового образа жизни;
- правильное питание;
- регулярный осмотр у врача;
- использование комфортного и натурального нижнего белья.
Основным фактором способствующим развитию кандидоза является нарушение работы иммунной системы, поэтому важно следить за состоянием своего здоровья и периодически употреблять витамины для предотвращения недостатка полезных микроэлементов. Также при любом дискомфорте рекомендуется в срочном порядке обращаться к врачу, это позволит предотвратить тяжелые осложнения и быстро вылечить нарушение.
Спровоцировать генитальный кандидоз способен грибок Кандида, который относится к условно-патогенным микроорганизмам и находится в малом количестве в организме каждого человека. При генитальном кандидозе у женщин повреждаются слизистые оболочки влагалища и половых губ, у мужчин отмечается грибковое поражение головки пениса. При ослабленной иммунной системе у человека появляются белесые выделения из половых органов, беспокоит зуд и другие проявления грибковой инфекции. Если своевременно не предпринять должного лечения, то вскоре молочница перейдет на другие органы и спровоцирует тяжелые осложнения.
Причины генитального кандидоза
Кандидоз влагалища у женщин отмечается намного чаще, нежели молочница на половом члене у мужчин.
Возбудителем является дрожжеподобный грибок рода Кандида, который имеется в организме каждого человека. Грибки находятся в ротовой полости, во влагалище, толстом кишечнике. При сильных защитных функциях иммунной системы, грибок пребывает в спящем состоянии, не размножается и не провоцирует развитие генитального кандидоза. Спровоцировать развитие генитального кандидоза способны недостаток витамина в организме, болезни хронического типа и другие неблагоприятные факторы, негативно влияющие на общее состояние здоровья пациента.
Кандидоз половых органов у женщин и мужчин проявляется при неблагоприятных факторах, которые значительно снижают защитные механизмы иммунной системы. В таком случае иммунитет не способен противостоять размножению грибков рода Кандида. Выделяют следующие факторы, при которых ослабевает иммунитет и проявляется генитальная молочница:
- продолжительное использование препаратов против депрессии, глюкокортикостероидных средств;
- при приеме антибиотиков, обладающих широким спектром действия;
- использование оральных противозачаточных средств на протяжении 2-х лет и более;
- резкая смена климата;
- постоянные перенапряжения и стрессовые ситуации;
- сезонные гиповитаминозы;
- нарушенный процесс обмена веществ;
- гормональные перестройки организма во время вынашивания ребенка, при климаксе или в подростковом возрасте;
- хронические болезни, провоцирующие воспалительные реакции в организме;
- ВИЧ-инфекции;
- последствия химиотерапии, которая проводилась по причине онкологического заболевания.
Как проявляется?
Генитальный кандидоз у женщин наблюдается гораздо чаще, нежели у представителей сильного пола. Это связано с особым строением половой системы, при которой грибкам легче проникнуть на слизистые оболочки половых органов. У женщины отмечается повреждение стенок влагалища, что провоцирует неприятные и болезненные ощущения при половом контакте. Нередко при генитальном кандидозе отмечается нарушение мочеиспускания, женщине больно сходить по-маленькому. Наблюдаются также такие симптомы:
- Выделения из влагалища. Консистенция выделений довольно густая и окрашена в белый цвет. Такой симптом является отличительной чертой генитального кандидоза. При этом отмечается плохой, кислый запах из половых органов.
- Жжение и зуд. Симптомы с особой силой проявляются за несколько дней до начала менструальных выделений. Отмечается сильное воспаление и покраснение половых губ.
Нередко отмечается такая усиленная клиническая картина, что женщине сложно уснуть в ночное время. В таком случае отмечается нервное истощение. Если вовремя не вылечить болезнь, то вскоре проявится кандидоз кожи в паху. Также молочница в области гениталий может привести к поражению шейки матки, что грозит прерыванием беременности или бесплодием в особо тяжелых случаях.
У представителей сильного пола кандидоз гениталий наблюдается реже, но отмечается также довольно неприятной симптоматикой. Сперва мужчина жалуется на дискомфортные и неприятные ощущения в области наружных половых органов. Затем появляются такие симптомы генитального кандидоза:
- повреждение слизистой оболочки полового члена, вызывающее ощущение зуда и жжения;
- белесый налет, образовавшийся на головке пениса и в районе крайней плоти;
- отечность на внутренней части мочеиспускательного канала;
- выделения белого цвета, обладающие кислым запахом.
Грибковая инфекция проникает на слизистые оболочки полового члена при половом акте или в процессе касания полового члена грязными руками, на которых присутствует грибок. У мужчин симптоматика более выраженная, нежели у женщин по той причине, что мочеиспускательный канал длиннее и уже. У представителей сильного пола, страдающих генитальных кандидозом, вскоре отмечается нарушение эрекции или полное отсутствие полового влечения, которое после адекватного лечения возобновляется.
Диагностика генитального кандидоза
Диагностировать молочницу в области гениталий несложно, важно как можно скорее обратиться к врачу. Мужчинам с генитальным кандидозом показана консультация у врача-уролога, женщинам следует обратиться к гинекологу. В таблице представлены основные методы, используемые при диагностике генитального кандидоза:
| Метод диагностики | Особенности |
| Сбор анамнеза и осмотр | Врачу для выяснения источника заболевания важно знать, имеются ли какие-то хронические болезни, подвергался ли пациент стрессам и другим неблагоприятным факторам. При осмотре гениталий удается выявить кандидоз и определить его степень. |
| Микроскопия мазка | Врач при осмотре влагалища или пениса берет мазок, который затем отправляет на микроскопическое исследование. Таким образом, удается подтвердить присутствие грибка Кандиды. |
| Бактериологический посев мазка | При диагностической процедуре определяется, насколько чувствителен грибок к разным типам антибактериальных средств. |
| Серологическое исследование | Проводится для выяснения, есть ли у пациента урогенитальное инфекционное поражение, поскольку нередко кандидоз сопровождается другими генитальными инфекциями. В таком случае будет отличаться терапия. |
Лечение патологии
Лечить кандидоз наружных половых органов необходимо с помощью препаратов местного и системного воздействия. К местным относятся кремы, мази, гели, вагинальные свечи и капсулы. Системно необходимо лечить кандидоз в более запущенном виде. Тогда врач назначает прием таблетированных препаратов. Если есть постоянный половой партнер, то терапия проводится сразу у обоих. Важно понимать, что кандидоз требует продолжительного времени на лечение.
Для лечения мужчин врач прописывает препараты, содержащие клотримазол. Препарат необходимо наносить 2 раза в день на головку пениса. Терапия длится 7 дней. Также возможно применение таких средств:
Чтобы устранить признаки генитального кандидоза у женщин назначают такие препараты:
Профилактика
Чтобы не допустить влагалищный кандидоз или молочницу полового члена, требуется регулярно проводить профилактику. Важно следить за состоянием иммунной системы, принимать витамины и минералы, чтобы избежать ее ослабления. При половых контактах рекомендуется использовать контрацептивные средства. Необходимо откорректировать режим питания и дня: рацион должен содержать полезные продукты, а ночной сон составлять не менее 8 часов. Следует ежедневно по 2 раза проводить подмывание, используя специальные средства, не нарушающие кислотность половых органов. При появлении первых неприятных признаков необходимо обращаться к врачу, поскольку возможны осложнения, при которых у человека возникнет кандидоз глаз, ротовой полости и распространение грибка в другие места.
Причины болезни и факторы риска
Молочница у мужчин на головке пениса — серьезное грибковое заболевание, которое требует специального лечения. Вызывает его дрожжеподобная колония грибков рода Candida.
Важно! Только врач — уролог в полной мере сможет определить кандидоз головки вашего члена и назначить адекватное лечение!
Формы болезни
Молочница на члене имеет две формы — острую и хроническую.
Острая форма, как правило, начинается сразу, резким проявлением первых симптомов и хорошо поддается лечению.
Хроническая форма носит длительный характер и проходит с периодами ремиссии (затишья) и рецидива (обострения). Хроническая форма не излечивается, проявления болезни можно лишь приостановить на какое-то время.
Молочница у мужчин и ее симптомы (как при этом выглядит головка полового члена)
Симптомы кандидоза крайне неприятны, особенно, если болезнь протекает не в скрытой (бессимптомной) форме. Вот основные из них, визуально различимые на головке члена:
- гиперимированные пятна, с мокнущей поверхностью и сероватым налетом;
- отечность головки и увеличение ее в размере;
- образование пузырьков и корочек;
- очаги воспаления и эрозии;
- микротрещины и микротравмы от расчесов;
- воспаление крайней плоти.
Осложнения болезни
Самолечение или неправильная терапия ведет к осложнениям — молочница детородного органа не только не исчезает, но и влечет за собой другие болезни. Среди них особо опасны:
При неправильном лечении поражения кандидозным грибком полового члена часто приводят к фимозу (болезненному сужению крайней плоти) и парафимозу (ущемлению головки полового члена), которые требуют операции в стационарных условиях.
Диагностика
Чтобы убедиться в достоверности предполагаемого диагноза обязательно сдайте анализы. Эта процедура позволит врачу определить стадию заболевания, исключить другие инфекции и сбалансировать терапию.
Чтобы анализ показал достоверный результат:
- сдается не раньше, чем через два часа после последнего мочеиспускания;
- мазок с поверхности крайней плоти желательно сдавать до принятия душа;
- посев крайне важно сдать до приема различных лекарственных средств.
Основные методы лечения
Вылечиться от молочницы помогут препараты разных форм. В основном это кремы, мази, растворы, а также таблетки и капсулы. Главный принцип — комплексный подход. Терапия включает в себя: противогрибковое, противовоспалительное, общеукрепляющее лечение.
Важно! Обычно мужчины чувствуют значительное улучшение уже после первого применения мазей, кремов и растворов. При этом молочница, а точнее – ее симптомы, исчезают с головки полового члена. Но это не повод прекращать лечение! Только результаты повторно сданных анализов могут подтвердить отсутствие болезни.
- Капсулы (таблетки)
- Флуконазол. Капсулы, применяемые для уничтожения любого вида молочницы. Быстро избавит от: зуда, жжения, болезненности и неприятных выделений.
- Форкан. Препарат действует через кровь, способствуя скорейшему выздоровлению.
- Фуцис. С помощью одной таблетки, пролонгированного действия можно вылечиться за семь дней.
- Пимафуцин. Суперпрепарат в капсуле для приема внутрь. Внимательно отнеситесь к дозе и последовательности приема.
Действие препаратов усилится, если:
- исключить, по возможности, половую активность на время лечения, использовать презерватив;
- ограничить себя от посещений общественных бассейнов, бань, саун;
- прилежно соблюдать личную гигиену: ежедневно (несколько раз в день) подмываться с жидким детским мылом слабым раствором фурациллина или перманганата калия;
Мыло в куске для подмывания не годится! Оно является разносчиком болезни!
- не пользоваться чересчур горячей или холодной водой для подмываний (чтобы, не вызвать усиление воспалительных процессов). Старайтесь смыть все выделения с крайней плоти;
- использовать дезинфицирующие порошкообразные средства: дерматол, стрептоцид или ксеноформ, чтобы подсушить мокнутие;
- нижнее белье выбирать по размеру, желательно из хлопка и ежедневно его менять;
- принимать витамины группы В и другие общеукрепляющие средства;
- отказаться от вредных привычек.
Общие рекомендации для скорейшего выздоровления
Не маловажную роль в лечении играет состояние иммунитета заболевшего. Поэтому неплохо его поддержать всеми возможными способами. В этом плане хорошо зарекомендовали себя травы: радиола розовая, касатик белый, элеутерококк, женьшень, омела белая, китайский лимонник.
Внимание! Применение лекарственных трав, как и лекарственных форм, возможно только после консультации с врачом.
Чтобы восстановить микрофлору предпочтительны препараты: Лактобактерин, Линекс, Бифидумбактерин.
- пиво, вино, квас;
- копчености;
- жареное и жирное;
- перец;
- соленья и маринады;
- кетчупы, майонез и соевый соус (все, что содержит уксус);
- сладкие фрукты и соки;
- сахар или мед;
- мучное и десерты.








